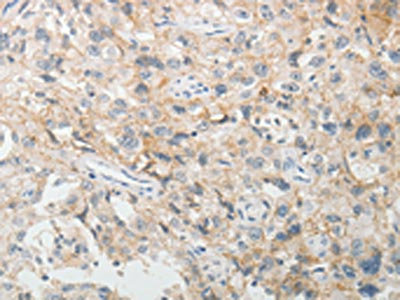

-
中文名稱:CDH3兔多克隆抗體
-
貨號:CSB-PA196946
-
規格:¥1100
-
圖片:
-
The image on the left is immunohistochemistry of paraffin-embedded Human lung cancer tissue using CSB-PA196946(CDH3 Antibody) at dilution 1/5, on the right is treated with fusion protein. (Original magnification: ×200)
-
The image on the left is immunohistochemistry of paraffin-embedded Human esophagus cancer tissue using CSB-PA196946(CDH3 Antibody) at dilution 1/5, on the right is treated with fusion protein. (Original magnification: ×200)
-
Gel: 8%SDS-PAGE, Lysate: 40 μg, Lane 1-2: HepG2 cells, mouse brain tissue, Primary antibody: CSB-PA196946(CDH3 Antibody) at dilution 1/100, Secondary antibody: Goat anti rabbit IgG at 1/8000 dilution, Exposure time: 1 minute
-
-
其他:
產品詳情
-
Uniprot No.:
-
基因名:
-
別名:CDH3; CDHP; Cadherin-3; Placental cadherin; P-cadherin
-
宿主:Rabbit
-
反應種屬:Human,Mouse
-
免疫原:Fusion protein of Human CDH3
-
免疫原種屬:Homo sapiens (Human)
-
標記方式:Non-conjugated
-
抗體亞型:IgG
-
純化方式:Antigen affinity purification
-
濃度:It differs from different batches. Please contact us to confirm it.
-
保存緩沖液:-20°C, pH7.4 PBS, 0.05% NaN3, 40% Glycerol
-
產品提供形式:Liquid
-
應用范圍:ELISA,WB,IHC
-
推薦稀釋比:
Application Recommended Dilution ELISA 1:1000-1:2000 WB 1:200-1:1000 IHC 1:5-1:20 -
Protocols:
-
儲存條件:Upon receipt, store at -20°C or -80°C. Avoid repeated freeze.
-
貨期:Basically, we can dispatch the products out in 1-3 working days after receiving your orders. Delivery time maybe differs from different purchasing way or location, please kindly consult your local distributors for specific delivery time.
-
用途:For Research Use Only. Not for use in diagnostic or therapeutic procedures.
相關產品
靶點詳情
-
功能:Cadherins are calcium-dependent cell adhesion proteins. They preferentially interact with themselves in a homophilic manner in connecting cells; cadherins may thus contribute to the sorting of heterogeneous cell types.
-
基因功能參考文獻:
- the evaluation of P-cadherin expression in lymph node metastases is an important predictor of disease outcome in breast cancer axillary lymph node metastases PMID: 28084338
- P-cadherin (CDH3) is highly dominant in both mouse and human retinal pigment epithelium in situ. The degree of dominance of P-cadherin is surprisingly large, with mouse Cdh3 and human CDH3 accounting for 82-85% and 92-93% of the total of the three cadherin mRNAs, respectively. PMID: 29338041
- Ophthalmologists should consider the diagnosis of CDH3-related retinopathy in individuals with such clinical features whether or not there is frank hypotrichosis. PMID: 26885695
- Adhesive dimerization of human P-cadherin catalyzed by a chaperone-like mechanism has been described. PMID: 27545624
- Results strongly advocated a pathogenic potential of the novel variants of CDH3 for the HJMD phenotypes. PMID: 27456782
- CDH3-related disease is characterized by a childhood-onset, progressive chorioretinal atrophy confined to the posterior pole. PMID: 27386845
- This study aimed to demonstrate the usefulness of mRNA expression levels of cadherin 3 (CDH3) in brush cytology specimens combined with cytology for the diagnosis of malignant biliary stricture PMID: 27399126
- CDH3 was negatively regulated at the genomic, transcriptional, and epigenetic level in PCa. PMID: 26771841
- The P-cadherin structure and packing arrangement provide new and valuable information towards the complete structural characterization of the cadherin dimerization pathway. PMID: 25849494
- In patients with breast infiltrating ductal carcinoma, P-cadherin was expressed in 40.5% of cases; P-cadherin expression had a negative relationship with the overall survival PMID: 26299056
- results establish a link between aberrant P-cadherin expression and hypoxic, glycolytic and acid-resistant breast cancer cells, suggesting a possible role for this marker in cancer cell metabolism PMID: 25269858
- Downregulation of P-cadherin expression appears to induce tumorigenicity in hepatocellular carcinoma. PMID: 25337260
- P-cadherin is able to potentiate ligand-dependent signaling of insulin-like growth factor 1 receptor in malignant keratinocytes and epidermal growth factor receptor in dysplastic cells. PMID: 25322858
- These findings indicate that HOXA9 contributes to poor outcomes in Epithelial ovarian cancer in part by promoting intraperitoneal dissemination via its induction of P-cadherin. PMID: 25023983
- The X-dimer plays a key role in the specific cell-cell adhesion mediated by human P-cadherin. PMID: 24559158
- Increased expression of CDH3 is associated with colorectal cancer. PMID: 23682078
- Loss of P-cadherin expression is associated with oral squamous cell carcinoma. PMID: 23740836
- P-cadherin and vimentin could be adjunctive to the commonly used immunohistochemical surrogates for basal-like breast cancer identification PMID: 24139214
- High CDH3 expression is associated with aggressive breast tumour behaviour. PMID: 23405208
- P-cadherin-mediated signaling is a melanocyte subtype-specific topobiological regulator of normal human pigmentation, possibly via GSK3beta-mediated canonical Wnt signaling. PMID: 23334344
- LA carcinomas and carcinomas negative for basal markers were more often negative for epithelial cell adhesion molecule (Ep-CAM) and P-cadherin PMID: 22531681
- Hypotrichosis associated with juvenile macular dystrophy is caused by mutations in CDH3, which encodes P-cadherin, a member of the classic cadherin family. PMID: 23143461
- P-cadherin regulates human hair growth and cycling via canonical Wnt signaling and transforming growth factor-beta2. PMID: 22696062
- Compared with conventional carcinomas, serrated adenocarcinomas showed no significant difference in P-cadherin staining. PMID: 22209340
- A novel nonsense CDH3 mutation in hypotrichosis with juvenile macular dystrophy PMID: 22348569
- High P-cadherin promotes liver metastasis and is associated with colon cancer. PMID: 21703417
- P-cadherin cooperates with insulin-like growth factor-1 receptor to promote metastatic signaling of gonadotropin-releasing hormone in ovarian cancer via p120 catenin. PMID: 21317933
- a novel splice site mutation (c.IVS10-1 G --> A) in intron 10, which leads to skipping of exon 11 in CDH3 gene in family with hypotrichosis with juvenile macular dystrophy PMID: 20140736
- P-cadherin positivity is associated with high-grade breast cancer subtypes and well-established markers of poor prognosis. PMID: 20852590
- Stable knockdown of P-cadherin in RT-112 cells diminished invasion and migration, and promoted intercellular adhesion PMID: 20473917
- Data conclude that P-cadherin counteracts the expression and function of myosin II-B, resulting in the suppression of the invasive and migratory behaviour of BLM melanoma cells. PMID: 20860798
- P-cadherin and CD24 are expressed in carcinomas of the biliary tract with high frequency and at an early stage of carcinogenesis. PMID: 20621328
- Overexpression of CDH3 is associated with basal-like phenotype in breast cancer. PMID: 19882246
- C/EBPbeta is able to up-regulate CDH3 promoter activity in breast cancer cells; the expression of P-cadherin linked with a worse prognosis of breast cancer patients PMID: 20385540
- 2 splice site mutations (one novel and one recurrent mutation) were in the CDH3 gene leading to hypotrichosis with juvenile macular dystrophy. PMID: 20203473
- P-cadherin gene expression proved to be a significant independent prognostic factor for both cancer-specific and recurrence-free survival in bladder cancer PMID: 20204300
- high levels of 80 kDa sP-cadherin in human milk. PMID: 11891861
- results point to the close relationship between the de novo expression of P-cadherin and the disruption of the cadherin/catenins complex with the squamoid phenotype of mucoepidermoid carcinoma of the thyroid (MECT) PMID: 12021924
- may play a central role in the development of endometriosis by mediating endometrial-peritoneal cell interactions in a homophilic manner PMID: 12112590
- Regulated expression of P-cadherin/beta-catenin complexes in ovarian tumor cells may represent a key step in disease progression PMID: 12800191
- Inappropriate PCAD expression in mouse mammary epithelium is compatible with normal mammary gland function. PMID: 12919105
- An absent P-cadherin expression could constitute a hallmark of aggressive biological behaviour in oral squamous cell carcinoma. PMID: 15375751
- In summary, we have ascertained a third gene associated with ectrodactyly and have demonstrated a hitherto unrecognised role of CDH3 in shaping the human hand PMID: 15805154
- A short truncated 50 kDa form of the N-terminal part of P-cadherin expresses in melanoma cell lines compared to melanocytes and keratinocytes. PMID: 15817166
- P-cadherin may have a role in progression of oral squamous cell carcinoma PMID: 15967043
- P-cadherin expression was strongly associated with tumor aggressiveness, being a good indicator of clinical outcome, and the aberrant expression of P-cadherin in breast cancer might be regulated by gene promoter hypomethylation. PMID: 16115928
- Novel heterozygous CDH3 mutations in hypotrichosis with juvenile macular dystrophy in two nonconsaguineous families. PMID: 17342797
- P-cadherin may be regarded as an additional immunohistochemical marker of basal-like breast carcinomas. PMID: 18074863
- P-cadherin is a newly defined transcriptional target gene of p63, with a crucial role in hair follicle morphogenesis as well as the apical ectodermal ridge during limb bud outgrowth in humans. PMID: 18199584
- Tunisian IBCs are characterized by frequent basal and ERBB2 phenotypes. Surprisingly, luminal inflammatory breast cancer also express the basal marker P-cadherin. PMID: 18230143
顯示更多
收起更多
-
相關疾病:Hypotrichosis congenital with juvenile macular dystrophy (HJMD); Ectodermal dysplasia, ectrodactyly, and macular dystrophy syndrome (EEMS)
-
亞細胞定位:Cell membrane; Single-pass type I membrane protein.
-
組織特異性:Expressed in some normal epithelial tissues and in some carcinoma cell lines.
-
數據庫鏈接:
Most popular with customers
-
-
YWHAB Recombinant Monoclonal Antibody
Applications: ELISA, WB, IHC, IF, FC
Species Reactivity: Human, Mouse, Rat
-
Phospho-YAP1 (S127) Recombinant Monoclonal Antibody
Applications: ELISA, WB, IHC
Species Reactivity: Human
-
-
-
-
-